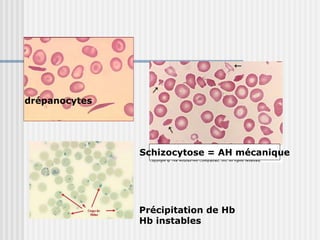

drépanocytes
Schizocytose = AH mécanique
Précipitation de Hb
Hb instables

Le document traite des anémies hémolytiques, indiquant une augmentation de la destruction des globules rouges pouvant être causée par des anomalies internes ou des agressions externes. La triade clinique se compose d'anémie, d'ictère et de splénomégalie, avec des symptômes pouvant varier de manière significative. Un diagnostic étiologique approfondi est nécessaire, basé sur des données cliniques et des tests biologiques, en tenant compte des antécédents médicaux et des contextes environnementaux.